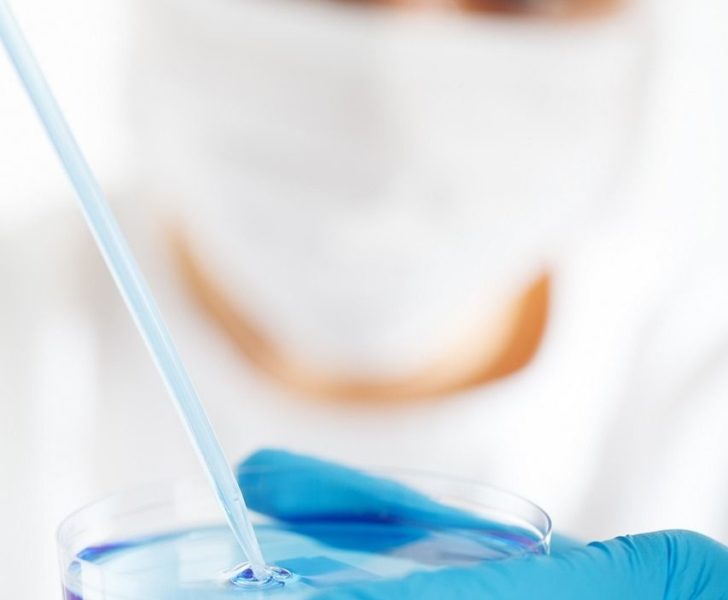

PFAS: Svårnedbrytbara kemikalier

PFAS, eller per- och polyfluorerade alkylsubstanser, har blivit ett ämne av stort intresse och oro i både miljö- och hälsodiskussioner världen över. Denna grupp av syntetiska kemikalier, vars överlevnad i miljön är nästan obestämd, har förmågan att påverka både människor och natur negativt. Eftersom de förekommer i en mängd av våra vardagsprodukter, växer medvetenheten och behovet av omfattande undersökningar och regleringar snabbt.
Vad är PFAS och var finns de?
PFAS är en samlingsbeteckning för tusentals industriellt framställda kemiska ämnen. De mest kända inom gruppen är PFOS (perfluoroktansulfonat) och PFOA (perfluoroktansyra). En av orsakerna till deras omfattande användning är deras exceptionella egenskaper. De är vatten- och fettavvisande, värmetåliga och extremt stabila. Dessa egenskaper gör dem attraktiva för användning i allt från stekpannor med non-stick-beläggning och regnkläder till brandsläckningsskum och kosmetika.
Trots deras funktionalitet är dessa kemikalier problematiska eftersom de inte bryts ner naturligt i vår miljö. På grund av detta hittar vi dem i jord, vatten och luft runt om i världen inklusive avlägsna områden som Arktis. Deras resistens mot att brytas ner har gått dem smeknamnet ”evighetskemikalier”.

Hälsorisker och reaktioner på PFAS-exponering
När människor exponeras för PFAS, om än i små mängder, finns det potentiella långsiktiga hälsokonsekvenser man bör beakta. Forskning har kopplat exponering för dessa kemikalier till diverse hälsoproblem. De kan påverka leverenzymnivåer, kolesterolnivåer och hormonbalanser. Det finns även indikationer på att PFAS kan försämra immunsystemets funktion och minska effekten av vacciner, särskilt hos barn.
Studier har dessutom föreslagit ett möjligt samband mellan PFAS och allvarligare hälsotillstånd som vissa cancerformer och sköldkörtelproblem. Symptomatiken är ofta subtil och utvecklas gradvis, vilket kan göra direkt koppling till PFAS svår utan noggranna tester.
PFAS i vårt dricksvatten och miljöåtgärder
En av de mest allvarliga bekymren kring PFAS är deras närvaro i dricksvatten. PFAS kan ansamlas i vattendrag och grundvatten där de ofta är svåra att avlägsna. Speciellt oroande är platser nära där dessa kemikalier används intensivt, som vid industriella processer eller i nära anslutning till övningsplatser för brandsläckning. Givet vikten av att skydda dricksvattenkvaliteten har Sverige och EU vidtagit flertalet åtgärder för att minska spridningen av dessa ämnen. Nationella riktlinjer och lagstiftningsinitiativ har tagits fram för att hantera problemet och skydda folkhälsan.
För att säkra vattenkvaliteten är detta en kritisk fråga som kräver kontinuerlig övervakning och analys. Här spelar laboratorietester en viktig roll. För den som är orolig över PFAS-halten i sitt vatten är det rekommenderat att konsultera experter, såsom företaget AK Lab, som specialiserar sig på att utföra kemiska analyser för att säkerställa att ditt vatten är fritt från dessa skadliga ämnen.











